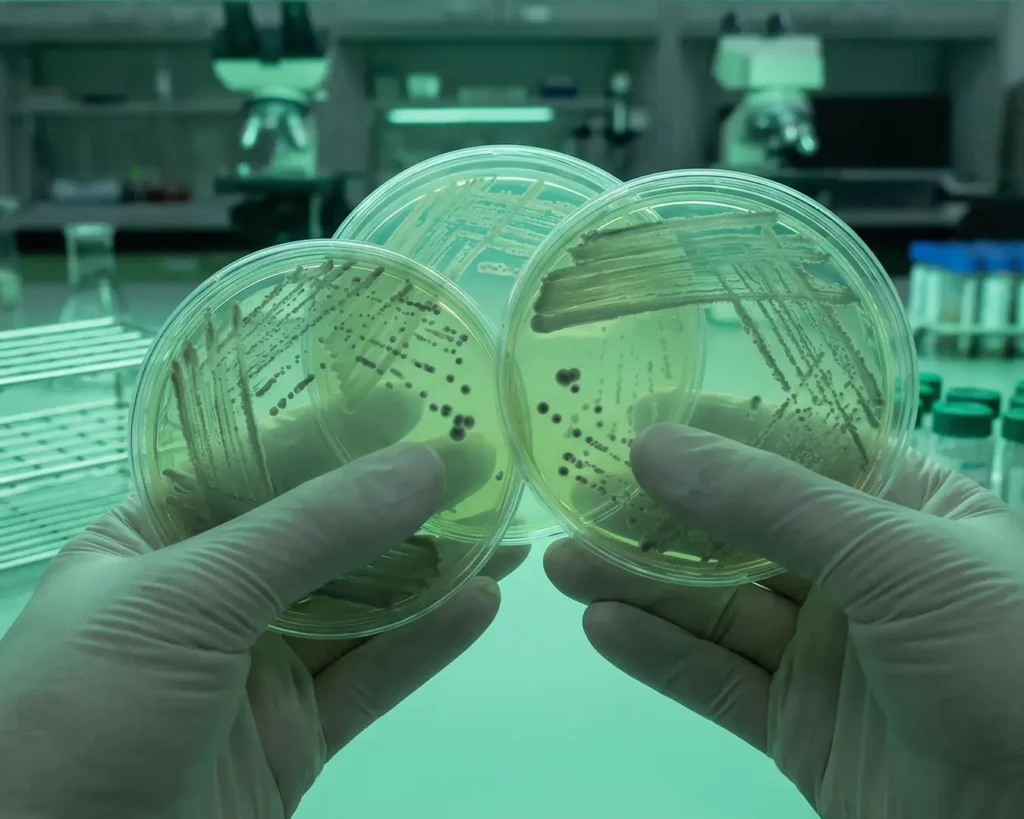

Não é porque é online
que precisa ser distante!
Aqui o aluno é protagonista e constrói o seu conhecimento.
Conheça nossas Pós-Graduações
O que nossos alunos dizem

Superou minhas expectativas, com os melhor corpo docente para administrar as aulas sendo referência em casa disciplina, está sendo maravilhoso.
Anderson
Aluno da pós

Estou me sentindo mais confiante com tudo o que venho aprendendo, e absorvendo.
Com certeza foi uma das minhas melhores decisões fazer essa pós.
Jéssica
Aluna da pós

Depois que comecei o curso da pós eu vejo algumas coisas da rotina laboratorial com outros olhos e até já estou pensando em fazer outra pós!!
Fabiana
Aluno da pós

Estou gostando muito da didática. Os conteúdos são passados com clareza e dedicação. Fiz uma ótima escolha ao me tornar uma aluna da Cursau.
Patrícia
Aluna da pós
Instituto Cursau © 2026 – Avenida Tiradentes, 501 – Sala 1002 – Londrina/PR – CNPJ: 48.532.389/0001-42